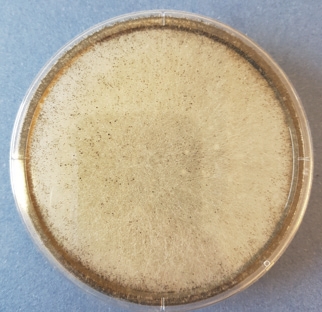
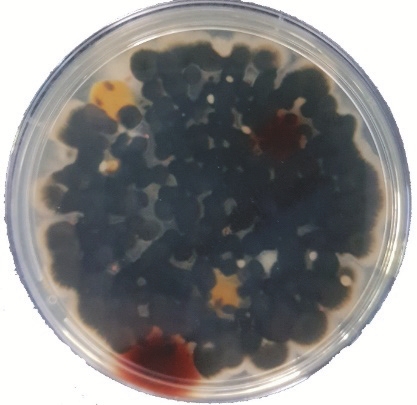
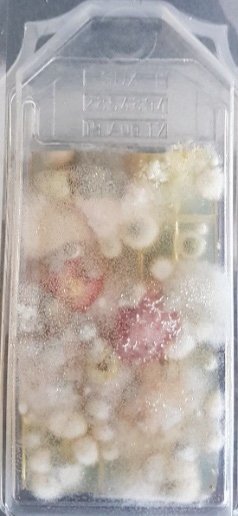

Die Anforderungen an die betriebseigene Qualitätssicherung, aber auch des Handels in Bezugnahme auf Haltbarkeiten (MHD), wie zur „nachweisbaren“ Hygienesicherheit (besonders pathogener Keime), ist aufgrund von aktuellen Meldungen drastisch gestiegen. Salmonellen & Listerien Rückrufaktionen in Rohmilchkäse, Colibakterien in Feta, etc., diese Meldungen werden immer häufiger!
Woran liegt das und wie können in der Milchwirtschaft, besonders im Käsebereich solche Szenarien verhindert werden?
- Durch den erhöhten Zeitbedarf für administrative Arbeiten zur Vorbereitung auf Audits, steht der QS die notwendige Zeit im laufenden Betrieb zu kontrollieren, nicht mehr ausreichend zur Verfügung.
- Eine definierte und den hygienischen Produktanforderungen gerecht werdendeKompetenzzuordnung (Matchball der QS) liegt meistens nicht vor.
- Das Klima, die baulichen Voraussetzungen, wie die prozesstechnischen Abläufe, haben einen ausschlaggebenden Einfluss auf die hygienische Produktqualität, werden aber zu wenig beachtet.
Hier ist das hygienische Qualitätsmanagement des Betriebes durch die Notwendigkeit einer darauf abgestimmte und sichere Betriebshygiene deutlich mehr gefordert. Das ureigenste Interesse der Betriebshygiene (unter gegebenen baulichen Bedingungen) muss also die Verringerung und Vermeidung „nachteiliger Beeinflussung“ mikrobiologischer, aber auch klimatischer Risikopotentiale (oft die Ursache für hygienische Risiken) sein, die von Gebäude, Einrichtungen, Anlagen, aber auch von Personal und den Produkten selber ausgehen.
Negative Begleiterscheinungen eines unzulänglichen Prozessumfeldes / Luftmanagements, sind z.B. die ungenügende Abführung innerer klimatischer Lasten (Feuchte, Wärme, etc.) und die daraus resultierende, unkontrollierte Verteilung im gesamten Prozessumfeld, auch raumübergreifend.Aber auch die feuchteintensiven Reinigungs- und Desinfektionsaufwendungen sind eine Ursache, den Raum in der zur Verfügung stehenden Zeit nicht ausreichend trocken zu bekommen. Hier gibt es neue Ansätze, mit natürlichen Substanzen als Alternativentkeimung über eine Kaltvernebelung, den feuchtebelastenden Schritt der chemischen Desinfektion, bei gleicher Hygieneabsicherung, aber mit deutlich weniger Feuchtigkeit durchzuführen, was das generelle Feuchteproblem im Raum signifikant reduziert.
RISIKOERKENNUNG / -ANALYSE IN ANLEHNUNG BRC / IFS ANALYSE IM LAUFENDEN PROZESS
Betrachtet man den linearen Prozessablauf in der Käseherstellung als eigenes System, so ergeben sich bei kybernetischer Betrachtung der Hygiene-klimatischen Umfeldvoraussetzungen, schnell Hinweise darauf, wo und wie sich hygienische Risiken ergeben.
Dazu kann mit einer einfachen Untersuchung linear zum Prozessablauf eine manifestierende hygienische Risikountersuchung, auch in Anlehnung BRC/IFS erfolgen, um mögliche Risiken schon im Vorfeld zu erkennen und geeignete Maßnahmen zu ergreifen, bevor (öffentlicher) Schaden entsteht.
Hier wird das hygienische Risiko zur Lebensmittelsicherheit/ Haltbarkeit als Beispiel genommen.
1 = gering z.B. Haltbarkeit> 3 Monate, umhüllte und verpackte Lebensmittel
2 = mittel z.B. Haltbarkeit > 1 Woche, stabilisiert o. unmittelbar nach Herstellung verzehrt
3 = hoch z.B. Haltbarkeit < 1 Woche, bestimmungsgemäßer Verzehr ohne Wärmebehandlung und zum Rohverzehr geeignet

Beispiel: Prozessablauf Natur gereifter Käse. Risikobereiche in rot
![]() Erfassung Hygienerisiko in Materialschleusen |
![]() Erfassung Hygienerisiko an der Zuluftanlage |
Grundlage ist immer die Bewertung des jeweiligen Produktes und der damit einhergehenden Zuordnung, ab welchem Verarbeitungsschritt die Risikopotentiale und zu erwartender Höhe vorliegen. Die in Anlehnung an BRC/IFS Food durchgeführten Risikobewertungen / Analysen zeigen auf:
- die bestehende hygienische Lebensmittelqualität und -Sicherheit
- das bestehende HACCP Konzept des Unternehmens (ausreichend?)
- sowie die vorliegende Hygiene (Hygienemanagement) im Betrieb
- sind die hygienische Risikogrundlage für Auditsschaffen auch die Basis für BCR
Balance between Chance & Risk

Messung der Oberflächenkeimbelastung innerhalb von Klimaanlagen und Lüftungsaggregaten im Reifebereich
Leitfaden zur Clusteruntersuchung der hygienischen Schwachstellen im Prozessablauf
- Produktionslogistik mit Produktionstechnik und Gebäudebeschaffenheit
- Prozessabläufe (z.B. Herstellung, Reifung, Konfektionierung)
- Prozesstechnik wie Slicer, Transportbänder, etc.
- Prozessumfeldtechnik, wie Kühlung, Lüftung, etc.
- Ablauf Reinigung / Desinfektion
- Mitarbeiterverhalten
= Analyse zur hygienischen Risikobewertung im laufenden Prozess
MIKROBIOLOGISCHE BELASTUNG IN REIFE- UND KONFEKTIONIERBEREICHEN

Hier sind oft nicht ausreichende Desinfektionsmöglichkeiten (auch korrosionsbedingt) an Prozessanlagen, wie während der Beschickung eingebrachte Umgebungskeime innerhalb der Reifebereiche eine Ursache
Erfassung von Luft- und Oberflächenbelastung (Risiko Crosscontaminationen)
Die Luft, wie auch Produkt berührende Oberflächen im Prozess, haben einen wesentlichen Einfluss auf mögliche Kontaminationen als hygienisches Risiko.
Visualisierung der vorliegenden Luftströmungen zur Darstellung der Druckverhältnisse (auch als Indikator zur Verschleppung innerer Lasten)
Die vorherrschenden Luftströmungen sind Indikator ob und wie sich Verschleppungen (innere Lasten, wie auch Keime) im Prozessfeld auf hygienische Risiken auswirken.
![]() |
![]() |
| Visualisierung der Luftströmungen zwischen unterschiedlichen Hygienebereichen | |
ABGESTIMMTER MASSNAHMENPLAN ZUR GEZIELTEN RISIKOMINIMIERUNG
Nach Abschluss der hygiene-klimatischen Prozessumfelddatenerfassung können aus den Ergebnissen sichere Optimierungsmaßnahmen abgeleitet werden, die auch im Einklang mit den internen Anforderungen, wie Grenzwerten abgestimmt sind.
Einbindung der Maßnahmen in das erweiterte HACCP
Anhand der Ergebnisse können an den vorher genommenen Messpunkten Hygiene und Klima verbessernder Maßnahmen/ Veränderungen technisch sowie operativ ausgelegt und bewertet werden. Auch stellen sich die notwendigen CCP für ein angepasstes HACCP transparent dar.
Durch die die gezielte Analyse des Prozessumfeldes in Vorgabe des linearen Prozessablaufes lassen sich die vorliegenden hygienischen Risikopotentiale transparent sicher bewerten und tragen durch die abgestimmten Maßnahmen der Optimierung zur erhöhten hygienischen Lebensmittelsicherheit bei.
Ein Beispiel ist die Anwendung einer neuen Hygienetechnologie auf Basis natürlicher Inhaltsstoffe, die über eine einfache Kaltvernebelung im Raum ausgebracht wird. Das Verfahren basiert damit auf physikalischen Gesetzmäßigkeiten, wie die Luft, gleichzeitig erreicht und entkeimt werden. Das Verfahren kann auch während der laufenden Produktion eingesetzt werden, was das Zeitfenster der hygienischen Absicherung dauerhaft auf 24/7 erweitern lässt. Zur Untersuchung wurden in den betroffenen Bereichen Luftkeimsammlungen, wie Oberflächenkeimteste durchgeführt. Diese wurden vor und nach Behandlung mit der neuen Hygienetechnologie ausgewertet.
Luftkeimmessungen |
||
![]() |
![]() |
![]() |
| Vor der Behandlung | Nach der Behandlung |
|
Oberflächenkeimmessungen |
||
![]() |
![]() |
![]() |
| Vor der Behandlung | Nach der Behandlung |
|
ZUSAMMENFASSUNG
Durch gezielte hygiene-klimatische Aufnahme des Prozessumfeldes in Vorgabe des linearen Prozessablaufes, lassen sich die vorliegenden hygienischen Risikopotentiale transparent sicher bewerten und tragen durch die abgestimmten Maßnahmen der (hygienischen) Optimierung zur erhöhten hygienischen Lebensmittelsicherheit bei. Auch hier gilt der Grundsatz „Kann ich das Klima & Luftströmungen steuern, habe ich Einfluss auf die Hygiene”.
RALF OHLMANN
… bildete sich nach einer Ausbildung
zum Metzger und Koch in den Bereichen
Lebensmitteltechnologie, Ernährungswissenschaften,
Betriebswirtschaft, Marketing
und Informationstechnik weiter.
Viele Jahre arbeitete er als Fachberater
für Prozesshygiene und Luftmanagement
in der Fleischwirtschaft.
Heute ist er Wissenschaftlicher Forschungsleiter
und CEO eines Luft- & Hygienefachinstitut
sowie Leiter der Bundesfachkommission
Agri & Food Business in
Berlin.

Anschrift des Verfassers
Ralf Ohlmann, Just in Air GmbH,
Erbrichterweg 17, 28357 Bremen